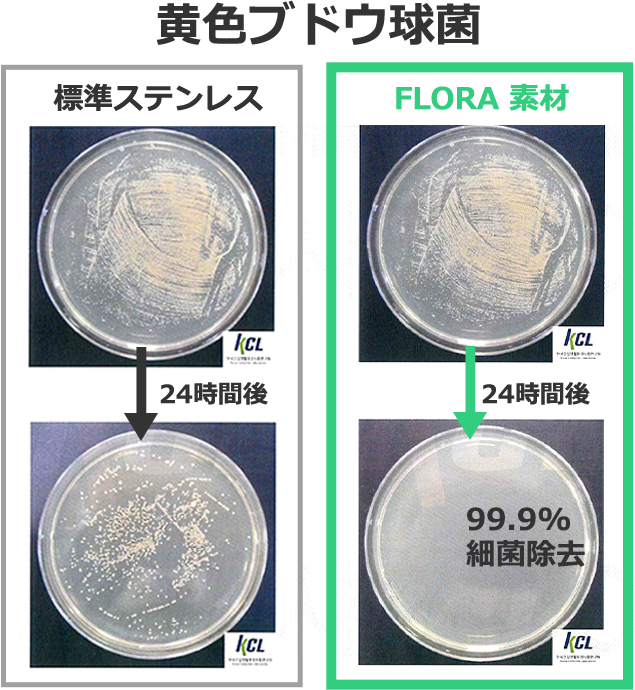

SDGsに即した画期的なキッチングッズ
~プラスチックの廃棄を抑制するステンレス容器~
プラスチック容器に代わる”世界初のレンジで使えるステンレス容器”に新シリーズFLORA誕生!
報道関係者各位
Aile-Ange(エールオーンジュ)(本社:東京都中央区、代表:田中奈々)は、世界初の電子レンジで使えるステンレス容器クイッティサン(正式名称:Cuitisan)の新シリーズFLORAの日本販売を2022年4月8日にCAMPFIREで開始いたしました。
Cuitisanシリーズは、ヨーロッパで2019年に販売開始、その後、世界33ヵ国で販売され、2022年3月までに累計出荷数130万個以上を達成しています。
当製品は、SDGsの目標12「持続可能な生産消費形態を確保する」の12.5:「2030 年までに、廃棄物の発生防止、削減、再生利用及び再利用により、廃棄物の発生を大幅に削減する。」に該当する画期的な製品となります。
■製品の特長
1.電子レンジ、オーブン、トースターで使用可能なステンレス製品!
Cuitisanの最大の特徴は、なんと言ってもステンレス製にもかかわらず電子レンジで使用可能ということです。従来のステンレスは電子レンジで使えないことが欠点の1つでありました。しかし、特殊ステンレスを使用することで、世界初、そして唯一の電子レンジでの使用ができるステンレス調理容器として開発されました。電子レンジ以外にも、オーブンやトースターなどでの使用も可能です!
従来のプラスチック容器では、食品の油汚れや匂い移りあり、洗ってもなかなか落ちない、電子レンジの加熱で変形する等の問題がありましたが、Cuitisanはその悩みを全て解決できます。
2.ドイツの検査機関TÜV Rheinlandで安全性認証済み!
Cuitisanは、厳しいことで有名なドイツの検査機関TÜV Rheinland(ドイツ安全認証機関)で、安全性を認証されています。世界初のCromoSteelの特殊ステンレスを使用することで、従来にない画期的な機能を有した調理容器として、ヨーロッパのシェフや主婦たちの間で大人気となっています。
3.SDGsに貢献。たった一つで3役。調理器具、食器、保存容器としてOK!
Cuitisanは電子レンジやオーブンで使えるため調理器具としても活用でき、食卓で食器としても使えます。更にはそのまま冷蔵・冷凍する保存容器としても使用でき、1つ3役としてプラスチック容器、食器の削減に貢献できます。
■新シリーズFLORAのさらなる進化ポイント
【すっきりスタッキング!】
Cuitisanの新シリーズ FLORAは、底面がラウンドで同じサイズの容器でも完璧にスッタキングできる形状のため、写真の通り収納スペースを大幅に削減することが可能です。4人家族など人数分のグラタン容器として4つそろえても、CuitisanのFLORAなら収納場所の確保に悩むことも無くなります。
【抗菌仕様で衛生的】
Cuitisanは、ステンレス抗菌仕様で非常に衛生的です。研究所KCLの結果では細菌の増殖を99.9%防止できる結果が得られました。プラスチックより衛生的で長寿命、その為、環境にも大変優しい製品です。
【CAMPFIRExMachiyaで先行販売開始!】
Cuitisan FLORAは、クラウドファンディングCAMPFIRE x Machiyaで先行販売が開始されました。
開始9分で目標販売金額を達成し、今後 2022年6月13日まで約2ヶ月間の期間限定の販売となっています。
プロジェクト: Cuitisan FLORA 限定先行販売
受付期間 : 2022年4月8日~6月13日
目標金額 : 100,000円
詳細URL : https://camp-fire.jp/projects/view/564934
【Cuitisan 日本正規代理店】
会社名 : Aile-Ange(エール・オンジュ)
代表者 : 田中 奈々
所在地 : 〒104-0061 東京都中央区銀座大竹ビジデンス 2F
電 話 : 050-5879-7746
URL : https://aile-ange.com/
【Cuitisan紹介動画】
参考画像データ
Aile-Ange(エールオーンジュ)(本社:東京都中央区、代表:田中奈々)は、世界初の電子レンジで使えるステンレス容器クイッティサン(正式名称:Cuitisan)の新シリーズFLORAの日本販売を2022年4月8日にCAMPFIREで開始いたしました。
Cuitisanシリーズは、ヨーロッパで2019年に販売開始、その後、世界33ヵ国で販売され、2022年3月までに累計出荷数130万個以上を達成しています。
当製品は、SDGsの目標12「持続可能な生産消費形態を確保する」の12.5:「2030 年までに、廃棄物の発生防止、削減、再生利用及び再利用により、廃棄物の発生を大幅に削減する。」に該当する画期的な製品となります。


■製品の特長
1.電子レンジ、オーブン、トースターで使用可能なステンレス製品!
Cuitisanの最大の特徴は、なんと言ってもステンレス製にもかかわらず電子レンジで使用可能ということです。従来のステンレスは電子レンジで使えないことが欠点の1つでありました。しかし、特殊ステンレスを使用することで、世界初、そして唯一の電子レンジでの使用ができるステンレス調理容器として開発されました。電子レンジ以外にも、オーブンやトースターなどでの使用も可能です!
従来のプラスチック容器では、食品の油汚れや匂い移りあり、洗ってもなかなか落ちない、電子レンジの加熱で変形する等の問題がありましたが、Cuitisanはその悩みを全て解決できます。
2.ドイツの検査機関TÜV Rheinlandで安全性認証済み!
Cuitisanは、厳しいことで有名なドイツの検査機関TÜV Rheinland(ドイツ安全認証機関)で、安全性を認証されています。世界初のCromoSteelの特殊ステンレスを使用することで、従来にない画期的な機能を有した調理容器として、ヨーロッパのシェフや主婦たちの間で大人気となっています。

3.SDGsに貢献。たった一つで3役。調理器具、食器、保存容器としてOK!
Cuitisanは電子レンジやオーブンで使えるため調理器具としても活用でき、食卓で食器としても使えます。更にはそのまま冷蔵・冷凍する保存容器としても使用でき、1つ3役としてプラスチック容器、食器の削減に貢献できます。


■新シリーズFLORAのさらなる進化ポイント
【すっきりスタッキング!】
Cuitisanの新シリーズ FLORAは、底面がラウンドで同じサイズの容器でも完璧にスッタキングできる形状のため、写真の通り収納スペースを大幅に削減することが可能です。4人家族など人数分のグラタン容器として4つそろえても、CuitisanのFLORAなら収納場所の確保に悩むことも無くなります。

【抗菌仕様で衛生的】
Cuitisanは、ステンレス抗菌仕様で非常に衛生的です。研究所KCLの結果では細菌の増殖を99.9%防止できる結果が得られました。プラスチックより衛生的で長寿命、その為、環境にも大変優しい製品です。

【CAMPFIRExMachiyaで先行販売開始!】
Cuitisan FLORAは、クラウドファンディングCAMPFIRE x Machiyaで先行販売が開始されました。
開始9分で目標販売金額を達成し、今後 2022年6月13日まで約2ヶ月間の期間限定の販売となっています。
プロジェクト: Cuitisan FLORA 限定先行販売
受付期間 : 2022年4月8日~6月13日
目標金額 : 100,000円
詳細URL : https://camp-fire.jp/projects/view/564934
【Cuitisan 日本正規代理店】
会社名 : Aile-Ange(エール・オンジュ)
代表者 : 田中 奈々
所在地 : 〒104-0061 東京都中央区銀座大竹ビジデンス 2F
電 話 : 050-5879-7746
URL : https://aile-ange.com/

【Cuitisan紹介動画】
参考画像データ






このプレスリリースには、メディア関係者向けの情報があります
メディアユーザーログイン既に登録済みの方はこちら
メディアユーザー登録を行うと、企業担当者の連絡先や、イベント・記者会見の情報など様々な特記情報を閲覧できます。※内容はプレスリリースにより異なります。
すべての画像
